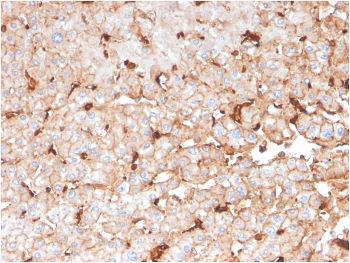
APOD Antibody / Apolipoprotein D

You have no items in your shopping cart.
- Kir2.1 Antibody (PerCP) [orb148335]Featured

AM, ICC, IF, IHC, WB
Human, Monkey, Mouse, Rat
Mouse
Recombinant
PerCP
100 μg - Cav3.2 Antibody (Biotin) [orb148212]Featured

AM, ICC, IF, IHC, IP, WB
Human, Mouse, Rat
Mouse
Monoclonal
Biotin
100 μg - Cav3.2 Antibody (FITC) [orb148213]Featured

AM, ICC, IF, IHC, IP, WB
Human, Mouse, Rat
Mouse
Monoclonal
FITC
100 μg - ERAS Rabbit Polyclonal Antibody (FITC) [orb102544]
IF
Bovine, Canine, Equine, Human, Mouse, Rat
Rabbit
Polyclonal
FITC
100 μl - mGluR5 Antibody (HRP) [orb150152]Featured

ICC, IF, IHC, IP, WB
Human, Mouse, Rat
Mouse
Monoclonal
HRP
100 μg - mGluR5 Antibody (PerCP) [orb150154]Featured

ICC, IF, IHC, IP, WB
Human, Mouse, Rat
Mouse
Monoclonal
PerCP
100 μg - mGluR5 Antibody (RPE) [orb150155]Featured

ICC, IF, IHC, IP, WB
Human, Mouse, Rat
Mouse
Monoclonal
RPE
100 μg - mGluR5 Antibody (APC) [orb150149]Featured

ICC, IF, IHC, IP, WB
Human, Mouse, Rat
Mouse
Monoclonal
APC
100 μg